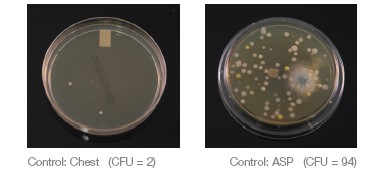

Mr. Thirsty® , an intraoral hands-free high-volume evacuation (HVE) suction device.
Experimental Design
Independent Variables: Use of a standard HVE, Mr. Thirsty® , Isodry® (Zyris),
Dry Shield® (DryShield), or Ivory® ReLeaf ™ (Kulzer)
Materials
Mr. Thirsty® (Zirc Dental Products), Isodry® (Zyris), Dry Shield® (Dry Shield), Ivory® ReLeaf ™ (Kulzer), Cavitron ultrasonic scaling unit with Cavitron FSI 10S 30K insert (Dentsply Sirona), HVE with standard suction tips, SAS Super 180 Bioaerosol Sampler, TSA with Lecithin and Poly 90 Contact plates, TSA Settling plates, patient volunteers (A, B, and C), licensed dental hygienist volunteer wearing a face shield, and Level 3 mask.
Methods
Each ultrasonic scaling procedure was completed while the office was closed, and all procedures were completed in one designated operatory. Prior to the first patient, HVE lines were cleaned with an evacuation line cleaner and traps were changed.
An additional saliva ejector line plus two HVE lines were running during the study to simulate a four operatory practice using a dual vacuum pump. The same dental hygienist performed all ultrasonic scaling procedures in this study. The ultrasonic scaler was consistently set to 60Hz and set to the highest water spray level. A control sample of the operatory air was taken for 5 minutes while patient A and the dental hygienist were seated in the room, prior to any aerosol generation. The control air sample was taken using the SAS Super 180 Bioaerosol Sampler with a TSA with Lecithin and Poly 90 Contact Plate (ASP, air sampling plate) placed 18 inches
from the patient’s mouth and a TSA Settling Plate placed on the patient’s chest 8 inches from their mouth (Chest SP).
The positioning of each plate was consistent for all testing for the duration of the study. For each ultrasonic scaling procedure, all quadrants of the mouth were treated, anterior and posterior, buccal and lingual. After 2 minutes, 30 seconds the devices were used on the opposite side of the mouth.
An ASP in the SAS Super 180 Bioaerosol sampler and HS Chest SP were used to routinely collect air quality samples for 5 minutes during each procedure and were replaced between each new condition.
Five separate conditions were utilized for comparison purposes on each patient volunteer. The first condition utilized a standard HVE, the second condition utilized Mr. Thirsty® , the third condition utilized Isodry®, the fourth condition utilized Dry Shield® , and the fifth condition utilized Ivory® ReLeaf ™.
There was a 10-minute room turnaround time between each patient, during which appropriate clinical contact surface cleaning and disinfection and other recommended protocols were followed. After each test run, the exposed plates were immediately processed and incubated at 37°C for 48 hours.
Microbial growth was analyzed and recorded for all plates. All testing procedures were repeated on a total of three patient volunteers. Before testing, all volunteers agreed to participate in the study and to having their photos taken.
Results
Air sampling plate (ASP) data and chest settling plate (Chest SP) data is presented below, showing individual data for the three patients.

Discussion
Overall, the data show a trend that the use of Mr. Thirsty® performed most similarly to HVE when considering both ASP and Chest SP results. It should be noted that all HVE devices used in this study reduced air sample bacterial counts when compared to the control air sample.
With respect to the Chest SP, an outlier was observed for Ivory® ReLeaf ™. Among the remaining hands-free devices, more variability was seen across the three patients with IsoDry® than for the other devices. Use of IsoDry® resulted in lower ASP CFU and the greatest variability was found for DryShield® .
Use of any HVE device holds clinical advantage; hands-free devices seem to be preferred by hygienists. There were some limitations in this study, including the limited number of patients.
A larger sample size could provide a better representation of the population, may reduce variability, and would enable determination of statistical significance. In addition, standardized laboratory testing in conjunction with clinical testing would be useful in future research.
Conclusion
Preliminary data in this pilot study showed Mr. Thirsty® to perform most similarly to a standard HVE in both air sampling and chest spatter plates while also giving the dental professional the advantage of utilizing a hands-free high-volume suction.


Article Published in Dental Solutions May/June 2023